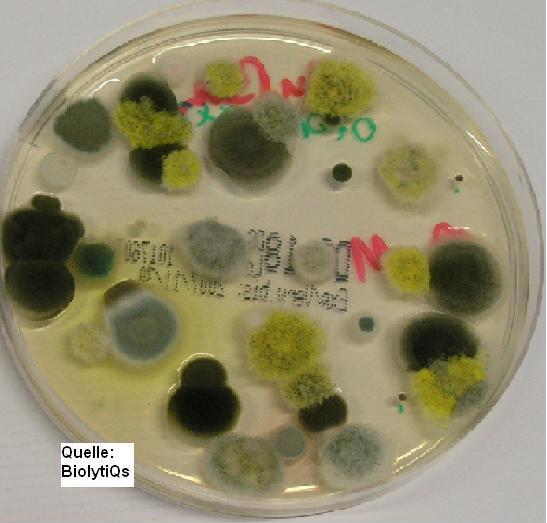
Mold life cycle

What Happens After an Instance of Water Damage? How Does Water Restoration Work? Every winter our phones ring off the hook as homeowners frantically reach out to us about frozen pipes that have burst, causing massive water damage to their homes. Water damage is very upsetting, and when it happens on a large scale, It’s